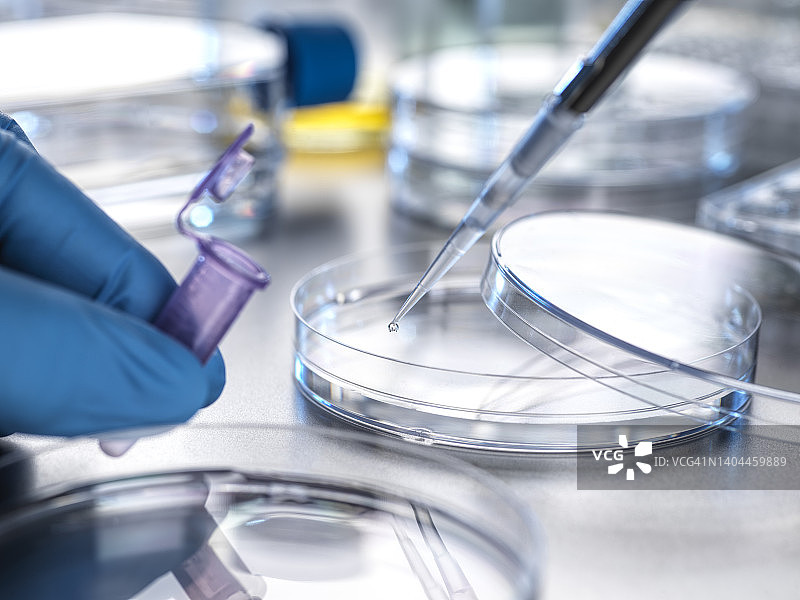

图片
- 图片
- 视频
- 音频
- 字体
科学家在实验室实验中将样品滴入小瓶
科学家在实验室实验中将样品滴入小瓶图片素材作品是由视觉中国旗下网站(VCG.COM)的图片品牌合作方:Westend61提供,作品作者是:Westend61/视觉中国;图片ID:VCG41N1404459889;最大规格:5500 x 4125 px (300ppi) | TIFF 64.91 MB;存储大小:3.27 MB - JPG;授权方式是:已取得肖像权和物权授权;当前图片素材提供下载与正版授权服务,助力您的品牌提升。
图片ID:VCG41N1404459889
作者/来源: Westend61/Getty Creative
品牌:Westend61
最大尺寸:5500 x 4125 px (300ppi) | TIFF 64.91 MB | 46.57 x 34.92 cm (18.33 x 13.75 in.)
存储大小:3.27 MB - JPG
第三方权利说明:已取得肖像权和物权授权
地点:英国
购买咨询
